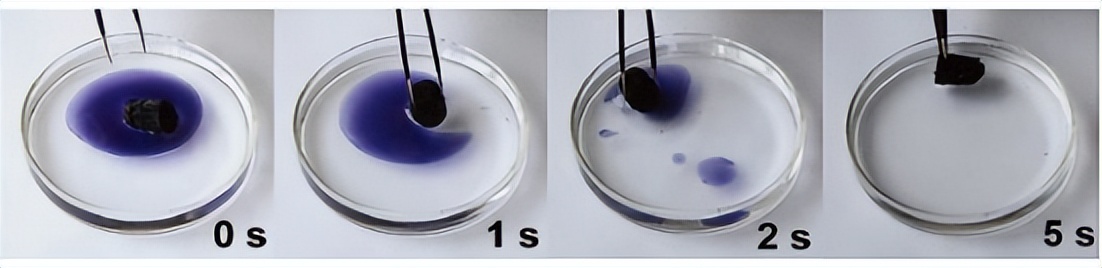
气凝胶制备方法_气凝胶材料特性_导电性树脂材料涂料

栏目:股票配资平台 作者:股票配资平台 更新:2026-02-25 阅读:110
<{股票配资平台}>你知道世界上最轻的固体是什么吗?{股票配资平台}>
这种材料不仅轻盈,还能在极寒与高温之间保持稳定,现已被广泛用于航天、能源、环保等领域。它,就是被誉为“世界上最轻的固体”的气凝胶。那么,它究竟是如何制造出来的?又有哪些特性呢?
气凝胶的诞生
气凝胶的历史可以追溯到上世纪三十年代。1931年,美国化学家 与同事打赌,想证明在不破坏凝胶微结构的情况下,可以用气体替代凝胶中的液体。然而,当时的难点在于,如果直接让液体蒸发,表面张力会让这些微小孔隙塌陷,最终破坏整个结构。

气凝胶之父——(图片来源:)
的解决办法是采用超临界干燥技术。他将凝胶加压加热,使内部液体进入超临界状态,再缓慢释放压力,让液体在没有液-气界面的情况下直接变成气体。这样,微小的骨架结构就被完整保留下来,第一块气凝胶由此诞生。最初的气凝胶材料是以二氧化硅为骨架的硅气凝胶,这一类型至今仍是应用最广泛的气凝胶品种。
什么是气凝胶?它有什么特性?
气凝胶是一类由凝胶衍生而来的超轻固体材料。它的基本结构是由一个三维的固体骨架支撑着无数微小的空隙,这些空隙几乎全部充满空气。换句话说,它是“凝胶的液体部分被气体替代”之后形成的产物。

扫描电镜下,气凝胶中复杂繁多的孔道结构(图片来源:)
扫描电镜下的气凝胶内部,像是一张由纳米级颗粒和细丝搭建起来的复杂网络,这种结构的孔径通常只有几十纳米,内部空隙率可以超过百分之九十九。也正是这种极端的多孔结构,让气凝胶具有许多惊人的性质。
气凝胶是如何制备的?
现代气凝胶的制备依然保留着与 时代类似的核心步骤。首先需要通过溶胶-凝胶反应制备出湿凝胶,骨架材料可以是硅酸盐、金属盐或有机高分子。湿凝胶中包含大量溶剂,这些溶剂需要在后续工艺中被空气替代。在干燥之前,往往要进行溶剂交换,将原有的水替换成更适合超临界干燥的液体,如乙醇或丙酮。这是为了降低临界温度和压力,使干燥过程更容易控制。

制备气凝胶的主流方法(图片来源:)
最后,将含有替代溶剂的湿凝胶放入高压釜,在高温高压下让溶剂进入超临界状态,然后缓慢降压,使其直接变为气体,留下完整的多孔固体骨架。这一过程虽然耗时且对设备要求高你知道世界上最轻的固体是什么吗?,但目前仍是获得高质量气凝胶的主流方法。
气凝胶有哪些类型?
虽然“气凝胶”这个词听起来像是一种单一材料,但实际上它包含了多种不同成分和性能的家族成员。
硅气凝胶:
气凝胶中最常见的类型导电性树脂材料涂料,透明度和隔热性能突出,常用于保温隔热和光学领域。
碳气凝胶:
由有机高分子或酚醛树脂热解而成,导电性良好,常用作超级电容器的电极材料。
金属氧化物气凝胶:
如氧化铁、氧化铝气凝胶,因其高比表面积和化学活性,被广泛应用于催化和磁性材料领域。
有机气凝胶:

以有机聚合物为骨架,机械强度较高,可加工性强,更适合需要柔韧性的应用场景。
卓越的隔热能力
气凝胶最广为人知的特性是其出色的隔热能力。由于内部几乎全是空气,且孔隙极其微小,它能够有效抑制热传导和对流,同时对红外辐射也有一定阻隔作用。这意味着在极薄的一层气凝胶材料中,就可以获得与厚重保温层相当的隔热效果。

气凝胶的耐热、隔热性能(图片来源:)
美国宇航局在火星探路者任务中,曾用气凝胶为探测器提供隔热保护,使其在火星昼夜温差极大的环境中依然能够正常工作。这种特性在地球上同样有用,如高性能建筑隔热板、工业设备的保温层,以及防护服的隔热衬里等,都开始引入气凝胶技术。
除了隔热,还有什么用?
尽管隔热是气凝胶的招牌功能,但它的潜力远不止于此。例如:
航天领域:
它被用作捕捉高速微粒的“太空网”,例如“星尘号”探测器成功利用气凝胶捕获了彗星尘埃并带回地球。

带有气凝胶样品采集器的“星尘号”太空舱返回地球(图片来源:)
环境治理方面:
疏水型气凝胶能高效吸附油类物质,用于清理海上溢油。
气凝胶吸附实验(图片来源:)
能源领域:
碳气凝胶由于其优异的导电性能和比表面积,被应用于超级电容器和储能系统。
高能物理领域:
气凝胶也能作为切伦科夫辐射探测器的一部分,用于粒子速度测量。
气凝胶正逐渐“飞入寻常百姓家”
过去,气凝胶因制造成本高、工艺复杂而远离普通人的生活。但随着技术进步,生产效率提高、原料成本下降,它正逐渐进入消费品领域。

气凝胶制成的御寒衣物展示(图片来源:)
如今,高端户外服装已经开始使用气凝胶复合材料来提供轻薄而高效的保暖功能;一些运动鞋在中底加入气凝胶隔热层,冬季运动时能更好地保持足部温暖;甚至保温杯和冰箱的隔热层也开始引入气凝胶,让保温效果在不增加厚度的情况下显著提升。

